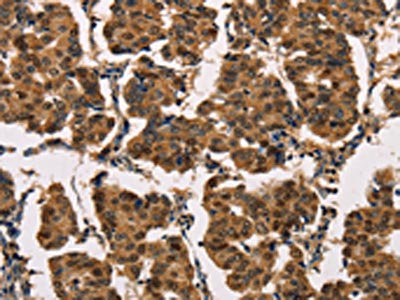

ATP7A Antibody
-
中文名稱:ATP7A兔多克隆抗體
-
貨號:CSB-PA444799
-
規(guī)格:¥1100
-
圖片:
-
The image on the left is immunohistochemistry of paraffin-embedded Human liver cancer tissue using CSB-PA444799(ATP7A Antibody) at dilution 1/50, on the right is treated with synthetic peptide. (Original magnification: ×200)
-
The image on the left is immunohistochemistry of paraffin-embedded Human breast cancer tissue using CSB-PA444799(ATP7A Antibody) at dilution 1/50, on the right is treated with synthetic peptide. (Original magnification: ×200)
-
-
其他:
產(chǎn)品詳情
-
Uniprot No.:
-
基因名:ATP7A
-
別名:ATP 7A antibody; ATP7A antibody; ATP7A_HUMAN antibody; ATPase copper transporting alpha polypeptide antibody; ATPase Cu++ transporting alpha polypeptide (Menkes syndrome) antibody; ATPase Cu++ transporting alpha polypeptide antibody; Copper pump 1 antibody; Copper transporting ATPase 1 antibody; Copper-transporting ATPase 1 antibody; Cu++ transporting P type ATPase antibody; DSMAX antibody; FLJ17790 antibody; MC 1 antibody; MC1 antibody; Menkes disease associated protein antibody; Menkes disease-associated protein antibody; Menkes syndrome antibody; MK antibody; MNK antibody; OHS antibody; OTTHUMP00000062077 antibody; SMAX3 antibody
-
宿主:Rabbit
-
反應(yīng)種屬:Human,Mouse,Rat
-
免疫原:Synthetic peptide of Human ATP7A
-
免疫原種屬:Homo sapiens (Human)
-
標(biāo)記方式:Non-conjugated
-
抗體亞型:IgG
-
純化方式:Antigen affinity purification
-
濃度:It differs from different batches. Please contact us to confirm it.
-
保存緩沖液:-20°C, pH7.4 PBS, 0.05% NaN3, 40% Glycerol
-
產(chǎn)品提供形式:Liquid
-
應(yīng)用范圍:ELISA,IHC
-
推薦稀釋比:
Application Recommended Dilution ELISA 1:2000-1:5000 IHC 1:50-1:200 -
Protocols:
-
儲存條件:Upon receipt, store at -20°C or -80°C. Avoid repeated freeze.
-
貨期:Basically, we can dispatch the products out in 1-3 working days after receiving your orders. Delivery time maybe differs from different purchasing way or location, please kindly consult your local distributors for specific delivery time.
-
用途:For Research Use Only. Not for use in diagnostic or therapeutic procedures.
相關(guān)產(chǎn)品
靶點詳情
-
功能:ATP-driven copper (Cu(+)) ion pump that plays an important role in intracellular copper ion homeostasis. Within a catalytic cycle, acquires Cu(+) ion from donor protein on the cytoplasmic side of the membrane and delivers it to acceptor protein on the lumenal side. The transfer of Cu(+) ion across the membrane is coupled to ATP hydrolysis and is associated with a transient phosphorylation that shifts the pump conformation from inward-facing to outward-facing state. Under physiological conditions, at low cytosolic copper concentration, it is localized at the trans-Golgi network (TGN) where it transfers Cu(+) ions to cuproenzymes of the secretory pathway. Upon elevated cytosolic copper concentrations, it relocalizes to the plasma membrane where it is responsible for the export of excess Cu(+) ions. May play a dual role in neuron function and survival by regulating cooper efflux and neuronal transmission at the synapse as well as by supplying Cu(+) ions to enzymes such as PAM, TYR and SOD3. In the melanosomes of pigmented cells, provides copper cofactor to TYR to form an active TYR holoenzyme for melanin biosynthesis.
-
基因功能參考文獻:
- we demonstrated that the restoration/preservation of autophagic-lysosomal degradation in senescent MEFs following rapamycin treatment correlated with attenuation of copper accumulation in these cells despite a further decrease in Atp7a levels. This study for the first time establishes a link between Atp7a and the autophagic-lysosomal pathway, and a requirement for both to effect efficient copper export PMID: 29579719
- the severity of MD correlate with cellular localization of ATP7A and support previous studies indicating that phosphorylation is crucial for the exit of ATP7A from TGN, while dephosphorylation is crucial for recycling back to TGN. PMID: 28389643
- We determined in silico that all the mutations leading to the classical Menkes disease leave no residual activity of ATP7A including the apparently less severe in-frame deletions. Whereas milder forms of the disease are characterized by mutations that allow a limited residual activity of ATP7A, including the nonsense mutation observed. PMID: 28451781
- Candidate RNAi screen revealed copper-transporting ATPase (ATP7A) as a target for inducing cisplatin sensitivity. PMID: 27806319
- Mnk inhibition enhances apoptotic activity of cytarabine in acute myeloid leukemia cells PMID: 27462781
- The authors conclude that the ATP7A interactome encompasses a novel Golgi-localized conserved oligomeric Golgi (COG) complex-dependent mechanism to specify neuronal development and survival. PMID: 28355134
- Mutation in ATP7A gene is associated with X-linked distal hereditary motor neuropathy. PMID: 27293072
- MNK orchestrates counterbalancing forces that regulate mTORC1 enzymatic activity. PMID: 28178522
- 11 single-nucleotide polymorphisms (SNPs) in CTR1, CTR2, ATP7A, and ATP7B were genotyped in these patients. PMID: 28737129
- The P-type copper ATPases ATP7A and ATP7B provide an important system for acquisition, active transport, distribution and elimination of copper. Relevance of copper metabolism to human diseases and therapy is already known. It is quite certain that further studies will reveal detailed and useful information on biochemical mechanisms and relevance to diseases PMID: 27896900
- the mechanism of copper-dependent regulation of ATP7B and ATP7A, the roles of individual MBDs, and the relationship between the regulatory and catalytic copper binding are still unknown. We describe the structure and dynamics of the MBDs, review the current knowledge about their functional roles and propose a mechanism of regulation of ATP7B by copper-dependent changes in the dynamics and conformation of the MBD chain. PMID: 28271598
- Deletion spanning exons 8 to 12 of the ATP7A gene is associated with a family affected with Menkes disease. PMID: 28397223
- ATP-dependent copper transfer in ATP7A/B is not affected by varying the pH, suggesting that net proton counter-transport may not occur in copper ATPases. Platinum anticancer drugs activate ATP7A/B and are subjected to ATP-dependent vectorial displacement with a mechanism analogous to that of copper PMID: 28164426
- studies show that merestinib effectively blocks eIF4E phosphorylation in AML cells and suppresses primitive leukemic progenitors from AML patients in vitro and in an AML xenograft model in vivo. PMID: 27307295
- It has been demonstrated in ovarian cancer cells that cisplatin resistance and uptake correlates with reduced CTR1 and LRRC8A protein expression/activity and a concomitant upregulation in cisplatin exporting transporters (ATP7A, ATP7B), which implies that the resistant cells have a reduced ability to accumulate cisplatin and activate proapoptotic transporters for osmolytes. PMID: 27112899
- Thus, ATP7A activity protects mitochondria from excessive copper entry, which is deleterious to redox buffers. Mitochondrial redox misbalance could significantly contribute to pathologies associated with ATP7A inactivation in tissues with paradoxical accumulation of copper PMID: 27226607
- CTR1, ATP7A, and lysyl oxidase were upregulated in the lung tissues and pulmonary arteries of mice with hypoxia-induced pulmonary hypertension and pulmonary arterial smooth muscle cells. PMID: 24614111
- A total of 11 different ATP7A mutations were identified in the 11 Korean families tested: 3 frameshift, 2 nonsense, 3 large deletions, 2 splice-site, and 1 missense mutation. PMID: 24919650
- Data suggest that even small amounts of functional ATP7A in subjects with genetic diseases associated with mutant ATP7A result in milder phenotypes; this includes Menkes disease, occipital horn syndrome, and X-linked distal motor neuropathy. [REVIEW] PMID: 25172213
- we demonstrate here that (1) AP complexes 1 and 2 of the CCV traffic machinery physically interact with ATP7A. PMID: 25574028
- Twenty-five novel mutations including duplications, missense, and splice site variants enable us to confirm the pathogenic role of ATP7A mutations in Menkes disease and occipital horn syndrome. PMID: 21208200
- This study demonstrated that G727R missense mutation may be relatively common in Korea. PMID: 24882692
- Depletion of CCC complex components leads to lack of copper-dependent movement of the copper transporter ATP7A from endosomes, resulting in intracellular copper accumulation and modest alterations in copper homeostasis in humans with CCDC22 mutations. PMID: 25355947
- This is the first time the activation of pseudo-exons is demonstrated in the ATP7A gene, and it demonstrates the usefulness of RNA analysis, in terms of revealing disease-causing mutations in noncoding regions. PMID: 24002164
- Normal male karyotypes without c.3914A>G mutation on ATP7A gene was showed. Postnatal genetic analysis and normal development confirmed the prenatal diagnosis. PMID: 24927440
- Two mutations in the copper transporter ATP7A (ATP7A-T994I and ATP7A P1386S-) lead to isolated distal motor neuropathy PMID: 24754450
- this article reviews the history and evolution of our understanding of disorders caused by impaired ATP7A function, and outline future challenges. [review] PMID: 24735419
- This is the first report of a synonymous ATP7A substitution being responsible forMenkes disease . PMID: 24100245
- Duodenal CTR1 mRNA and protein expression was decreased in Wilson's disease patients, while ATP7A mRNA and protein production was increased. This can be a defense mechanism against systemic copper overload resulting from functional impairment of ATP7B. PMID: 23963605
- enhanced expression of Anx A4 confers platinum resistance by promoting efflux of platinum drugs via ATP7A. PMID: 24150977
- Decreased gene expression of ATP7A is associated with drug resistance in cervical cancer. PMID: 24403508
- Trafficking of the Menkes copper transporter ATP7A is regulated by clathrin-, AP-2-, AP-1-, and Rab22-dependent steps. PMID: 23596324
- Cisplatin binds to the copper-binding sites in the N-terminal domain of ATP7B; this binding may be an essential step of cisplatin detoxification involving copper ATPases. PMID: 23751120
- COX19 is necessary for the transduction of a SCO1-dependent mitochondrial redox signal that regulates ATP7A-mediated cellular copper efflux. PMID: 23345593
- ATP7A mutations leading to Menkes disease and occipital horn syndrome in human and animal models [Review] PMID: 23281160
- Tree males in a family with Menkes disease showed a missense mutation in an exon 8 splicing enhancer and equally reduced amounts of ATP7A transcript. PMID: 17496194
- review of ATP7A function to maintain intracellular copper levels and incorporate copper into copper-dependent enzymes PMID: 17989919
- Sec61beta-KD cells also exhibited altered ATP7A cellular distribution. PMID: 22710939
- findings illuminate the mechanisms underlying ATP7A-related distal motor neuropathy and establish a link between p97/VCP and genetically distinct forms of motor neuron degeneration PMID: 22210628
- ATP7A overexpression played an important role in platinum-resistance of non-small cell lung cancer. PMID: 22304828
- Partial ATP7A gene duplication was identified in 20 unrelated Menkes patients including one patient with Occipital Horn Syndrome (OHS) are estimated from our material to be the disease causing mutation in 4% of the Menkes disease patients. PMID: 22074552
- Clusterin and COMMD1 independently regulate degradation of the mammalian copper ATPases ATP7A and ATP7B. PMID: 22130675
- Binding of canine copper toxicosis protein COMMD1 partially restored the expression, subcellular localization, and copper-exporting activities of the ATP7A mutants. PMID: 21667063
- The lumenal loop Met672-Pro707 of copper-transporting ATPase ATP7A binds metals and facilitates copper release from the intramembrane sites. PMID: 21646353
- 33 novel splice site mutations in ATP7a gene detected in patients with Menkes disease, are described. PMID: 21494555
- Clusterin (apolipoprotein J), a molecular chaperone that facilitates degradation of the copper-ATPases ATP7A and ATP7B. PMID: 21242307
- MNK and WND were differentially localised within the placenta. PMID: 21115196
- The results of this study indicate that the A629P mutation of ATP7A does not have appreciable affects on the stability of copper-bound states but rather destabilizes the characteristic end-to-end beta-sheet. PMID: 20714486
- Disturbances of ATP7A and ATP7B function caused by mutations lead to severe metabolic diseases Menkes and Wilson diseases, respectively. PMID: 21117320
- Conclude that novel Atp7a protein variants may exist in human intestinal epithelial cells, with different intracellular locations and potentially distinct physiological functions. PMID: 19679821
顯示更多
收起更多
-
相關(guān)疾病:Menkes disease (MNKD); Occipital horn syndrome (OHS); Distal spinal muscular atrophy, X-linked, 3 (DSMAX3)
-
亞細胞定位:Golgi apparatus, trans-Golgi network membrane; Multi-pass membrane protein. Cell membrane; Multi-pass membrane protein. Melanosome membrane; Multi-pass membrane protein. Early endosome membrane; Multi-pass membrane protein. Cell projection, axon. Cell projection, dendrite. Cell junction, synapse, postsynaptic density.; [Isoform 3]: Cytoplasm, cytosol.; [Isoform 5]: Endoplasmic reticulum.
-
蛋白家族:Cation transport ATPase (P-type) (TC 3.A.3) family, Type IB subfamily
-
組織特異性:Widely expressed including in heart, brain, lung, muscle, kidney, pancreas, and to a lesser extent placenta. Expressed in fibroblasts, aortic smooth muscle cells, aortic endothelial cells and umbilical vein endothelial cells (at protein level).; [Isoform
-
數(shù)據(jù)庫鏈接:
Most popular with customers
-
-
YWHAB Recombinant Monoclonal Antibody
Applications: ELISA, WB, IHC, IF, FC
Species Reactivity: Human, Mouse, Rat
-
Phospho-YAP1 (S127) Recombinant Monoclonal Antibody
Applications: ELISA, WB, IHC
Species Reactivity: Human
-
-
-
-
-